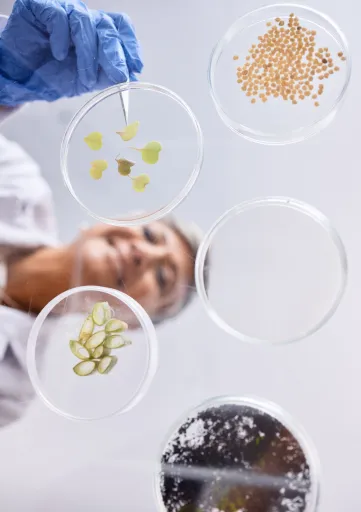

Mic2Food - Acceleració de la innovació i el desenvolupament d'aliments microbians europeus
Codi
2024_Mic2Food
Grup de recerca
Cuina i Gastronomia
Línia de recerca
Innovació i Creativitat en Gastronomia
Descripció del projecte

Organització de finançament
COST | European Cooperation in Science and Technology
Convocatòria
EU COST Programme (CA24132)
2025-2029
Aquesta COST Action té com a objectiu facilitar el desenvolupament de nous aliments microbians per al mercat europeu. Mic2Food crearà una xarxa única amb una distribució geogràfica equilibrada per abordar els reptes científics i tecnològics per fer realitat els substituts microbians dels aliments. Col·lectivament, Mic2Food té com a objectiu:
- Aïllar i identificar nous microorganismes no patògens amb les propietats desitjades per a la seva aplicació com a aliments microbians, inclòs el seu contingut proteic i la composició lipídica, i el contingut de micronutrients, i optimitzar les seves propietats de producció d'acord amb les regulacions alimentàries.
- Desenvolupar i ampliar els seus processos de producció des de l'escala de laboratori fins a l'escala pilot.
- Establir un processament posterior (DSP), per exemple, eliminació d'ARN, i formulacions per produir productes atractius que es puguin comercialitzar.
- Supervisar els canvis normatius per als aliments microbians i facilitar la comercialització de productes alimentaris microbians a Europa i a tot el món.
- Quantificar les propietats nutricionals i mecàniques de les soques microbianes i els productes alimentaris de manera estandarditzada durant tot el desenvolupament.
- Accelerar la traducció de la recerca acadèmica a productes tangibles mitjançant una estreta col·laboració amb socis industrials establerts.
Consulta la web del projecte: https://www.cost.eu/actions/CA24132/
Imatge

Galeria d'imatges